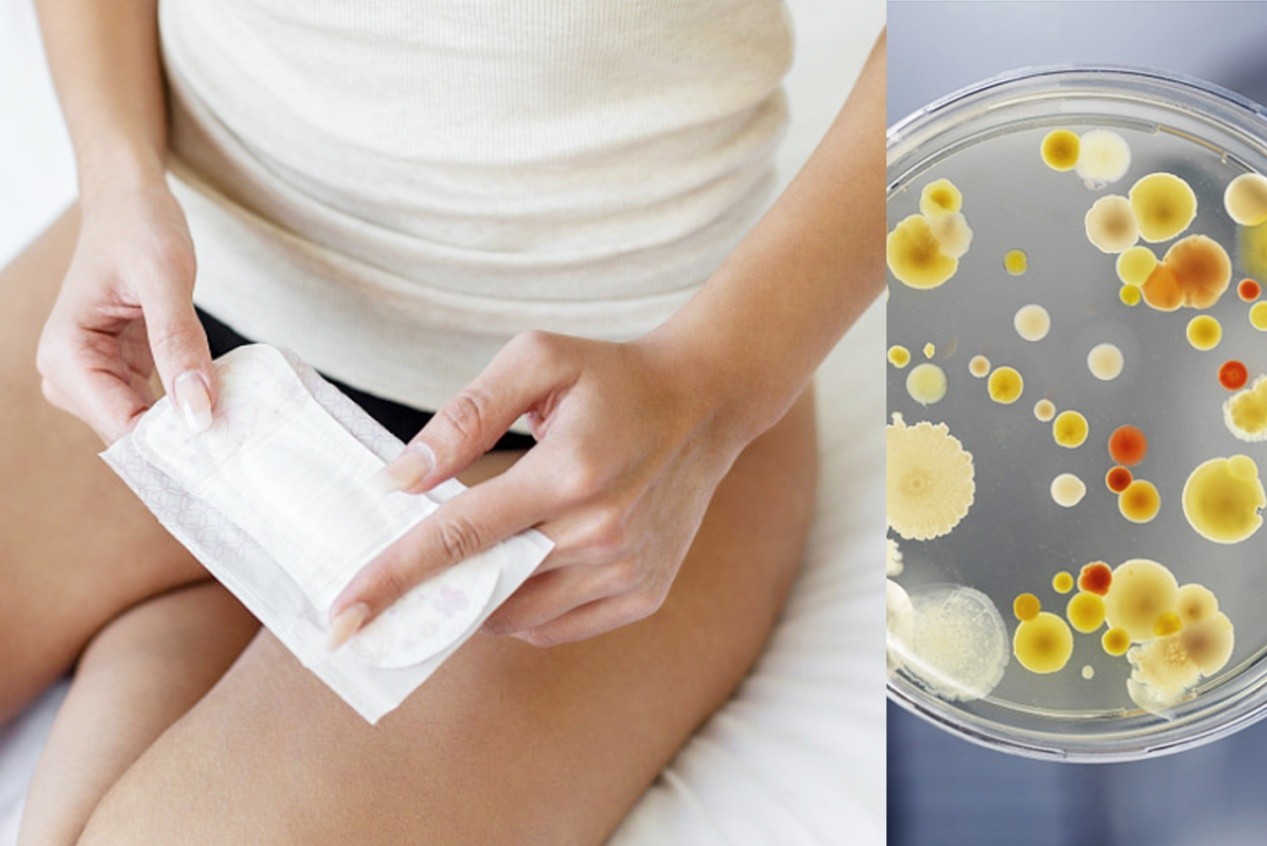
7个不起眼行为正掏空你的肾脏,十个不起眼的小习惯其实很伤身

文|王sir
编辑|媸尤
- 在阅读此文前,诚邀您点击一下“ 关注 ”,既方便您进行讨论与分享,又给您带来不一样的参与感,感谢您的支持。
小李是一个28岁的女生,平时因为工作原因经常久坐不动,但是坐久了她就会感觉阴部的分泌物增多并伴有异味,这让小丽感觉到非常的尴尬。
于是她每天回到家都会清洗阴部,但是这样的做法并没有让她的症状有所缓解。
然后她去了医院寻求医生的帮助,医生告诉她她过度清洁阴部的行为是不正确的,那么在日常生活中,我们的哪些行为实际上在损害阴道健康呢?
私密部位对于女性同胞来说非常的重要,以下是给大家的一些建议:
第一点就是避免使用刺激物,不要使用含有化学药品的沐浴露或清洁剂清洗*处私**, 因为这些化学成分可能会破坏阴部区域的自然pH平衡,导致感染和其他健康问题。
相反,应该选择天然的、温和的清洁产品,如甘油皂或基于益生菌的清洁剂,但是也不要像上述例子中的女士一样过度清洁。

第二点是避免*交性**后过长时间不清洗,一些人在*交性**后往往习惯不立即清洗*处私**,这会使细菌滋生,增加尿道感染和其他疾病的风险。
一旦完成了*爱性**,建议及时清洗阴道。可以使用温水或男性避孕套上的润滑剂来帮助减少摩擦,从而减轻阴道的不适。
另外许多没有怀孕的女人在同房时都会使用安全套。市场上最普通的安全套里,都含有一种叫做甲基硅油的润滑剂。

甲基硅油为弱碱,在应用时不容易挥发,在水中不溶解。如果这些物质长时间滞留在女人的阴道内,不仅会对女人的阴道环境造成损害,还会对女人的生殖系统造成影响。
第三点是避免穿紧身裤和*裤内**,穿厚重紧身裤和紧身*裤内**容易导致私部闷热潮湿,这会创造优越的湿度, 促进细菌繁殖并引起异味。
应尽量选择吸汗快干并透气性好的棉质*裤内**以保持阴道干燥。当然我们也要勤换*裤内**避免大量细菌滋生,特别注意的是当天换下来的*裤内**最好当天清洗。

第四点是不要在非经期的时候使用护垫,现在市场上的护垫大多都是用不知名的香精做的。
而且护垫主要是以化纤为主,很少有纯棉的护垫,如果长时间使用,护垫中的这些物质会对阴道造成一定的伤害,从而引起阴道问题。
第五点是避免擦掉阴毛,为了清洗*处私**或减少异味,一些女性会进行擦拭或刮除阴毛。但是,这么做的后果会导致感染和引起皮肤炎症。
更好的方法应当在沐浴时适当清洗*处私**,并使用专门的修剪器修剪干净。

当然以上的都是预防措施,那么如果我们平时没有注意到这些问题,会引发哪些疾病呢?
如果不重视阴道健康,可能会导致以下疾病的发生:阴道感染,阴道感染是由细菌、真菌或其他微生物引起的感染,通常导致阴道瘙痒、灼热、异味和分泌物增加等症状。
未得到及时治疗,它们可能最终发展成更严重的炎症性疾病。
尿路感染,尿路感染是另一种常见的阴道相关疾病,它是由细菌感染膀胱、肾脏或输尿管引起的。 此类感染会引起如频尿、尿急、尿道刺痛以及尿不尽等症状。

还有细菌性阴道炎,这是一种普遍的炎症性疾病,以 外阴瘙痒、恶臭、分泌物异常为特殊表征, 原因可能是由三种病菌如芽殖球菌、革兰氏阴性杆菌和厌氧菌同时作用。
另外还有念珠菌感染,念珠菌感染是由念珠菌引起的真菌感染。它是一种常见的阴道感染,可以导致瘙痒和灼热,并在外阴观察到小的凸起物或白色斑块。
尽管这较为常见,但严重的部分性生殖健康问题包括盆腔炎、宫颈炎,甚至会造成女性不孕等。
长期忽略女性*处私**卫生可能会造成身体健康上的隐患,所以应该及时的寻求专业医生的建议和治疗。

其实我们还应该在日常生活中锻炼并保持健康体重,适当的身体活动能够提高血液循环,增强免疫力。
选择适合自己的运动如慢跑、游泳或者跳有氧操可以行之有效地防止*处私**疾病和衰退,希望每个女生都能有个健康的身体。
对此,您有什么想说的呢?欢迎在评论区留下您的看法!